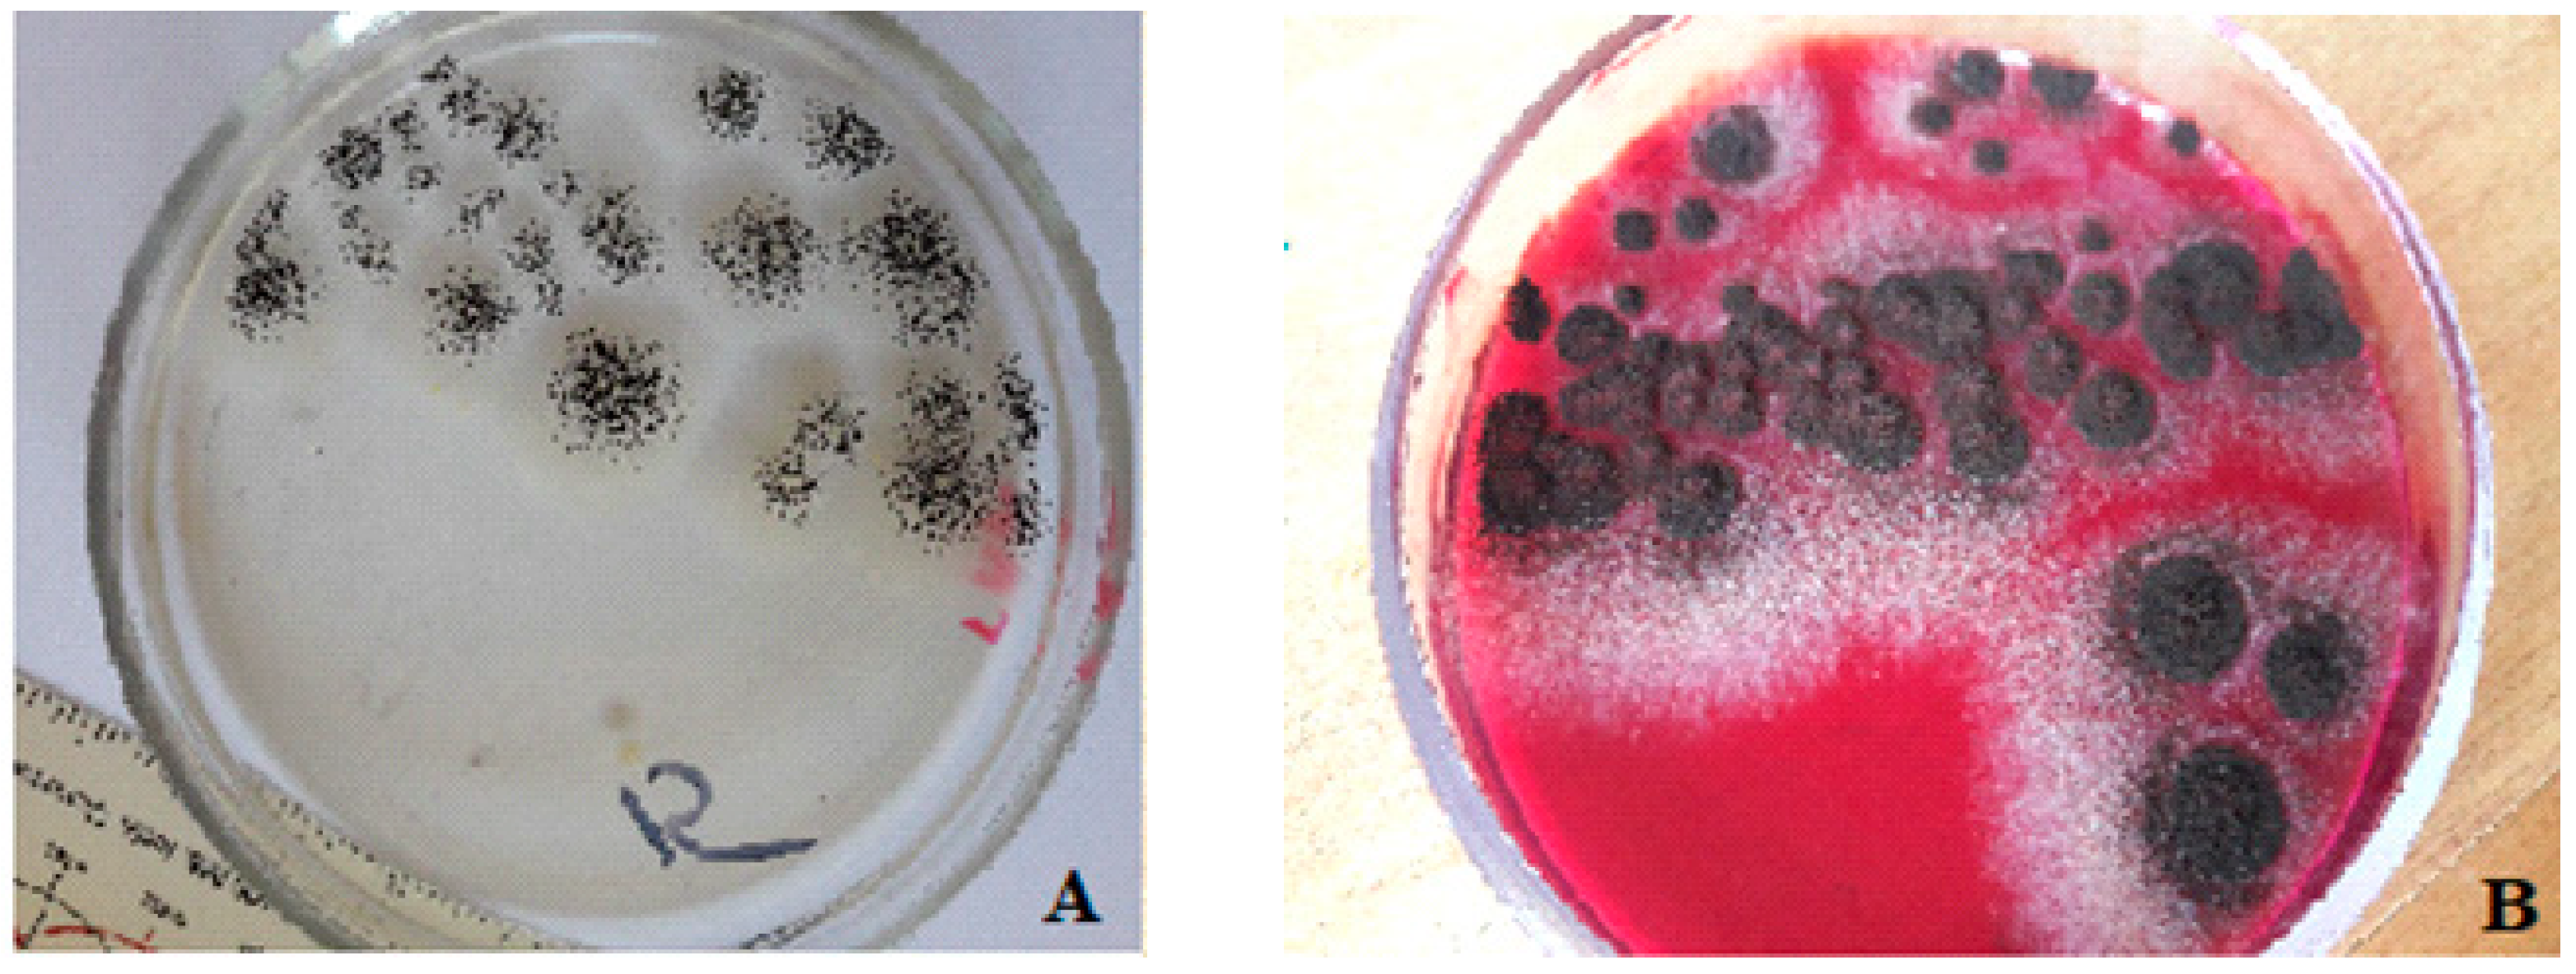
Polymers 14 03275 g013

Ecotoxicity Study of New Composite Materials Based on Epoxy Matrix DER-331 Filled with Biocides Used for Industrial Applications
Abstract
:1. Introduction
2. Materials and Methods
2.1. Technology of the Composite Material Formation
- the preliminary preparation and dosing of ingredients
- the heating of epoxy resin DER-331 to a temperature of T = (373 ± 2) K and exposure for a specified time τ = (20 ± 0.1) min
- the mechanical mixing of ingredients during τ = (1.5 ± 0.1) min
- the ultrasonic treatment (UST) of the composition during τ = (1.5 ± 0.1) min;
- the cooling of the composition to room temperature T = (273 ± 2) K, during τ = (60 ± 5) min
- the adding the hardener TETA and mixing the composition for a time τ = (5 ± 0.1) min
- the application of the composition by mechanical or pneumatic spraying.
- the solidification of materials according to the experimentally established regime
- the formation of samples and their keeping during t = (12.0 ± 0.1) h at a temperature T = (293 ± 2) K
- heating at a rate of υ = 3 K/min to a temperature of T = (393 ± 2) K
- the keeping of the samples at a given temperature for a time t = (120 ± 5) min
- slow cooling to a temperature of T = (293 ± 2) K.
2.2. Study of the Structure, Microrelief, and Chemical Composition of the Composite Surface
2.3. Ecotoxicity Test Methods
2.4. Microbiological Methods for Studying Biofilm Formation
2.5. Statistical Methods
3. Results
3.1. Mathematical Planning of the Experiment
3.2. The Structure and Microrelief of Surfaces
3.3. The Chemical Composition of the Composite Surface
3.4. Ecotoxicity Analysis of Polymer Coatings with Biocidal Fillers
3.5. Analysis of Biofilm Formation on Polymer Coatings with Biocidal Fillers
4. Conclusions
5. Perspectives for Future Research
Author Contributions
Funding
Institutional Review Board Statement
Informed Consent Statement
Data Availability Statement
Conflicts of Interest
References
- Ntona, M.; Schröder, M. Regulating oceanic imaginaries: The legal construction of space, identities, relations and epistemological hierarchies within marine spatial planning. Marit. Stud. 2020, 19, 241–254. [Google Scholar] [CrossRef]
- Alamoush, A.S.; Ballini, F.; Ölçer, A.I. Revisiting port sustainability as a foundation for the implementation of the United Nations Sustainable Development Goals (UN SDGs). J. Shipp. Trd. 2021, 6, 19. [Google Scholar] [CrossRef]
- Tseliou, F.; Tselepides, A. The importance of the ecosystem approach in the management of the marine environment. EuroMediterr. J. Environ. Integr. 2020, 5, 22. [Google Scholar] [CrossRef]
- Mikhailov, V.V.; Andryukov, B.G.; Lyapun, I.N. Search and Selection of Bacteriocin-Producing Strains of Marine Bacteria in the Aquatic Ecosystems of the Sea of Japan. Mol. Genet. Microbiol. Virol. 2019, 34, 216–219. [Google Scholar] [CrossRef]
- Campagne, C.S.; Langridge, J.; Claudet, J.; Mongruel, R.; Thiébaut, E. What evidence exists on how changes in marine ecosystem structure and functioning affect ecosystem services delivery? A systematic map protocol. Environ. Evid. 2021, 10, 36. [Google Scholar] [CrossRef]
- Asprogerakas, E.; Lazoglou, M.; Manetos, P. Assessing land–sea interactions in the framework of maritime spatial planning: Lessons from an ecosystem approach. EuroMediterr. J. Environ. Integr. 2020, 5, 18. [Google Scholar] [CrossRef]
- Hahladakis, J.N. Delineating and preventing plastic waste leakage in the marine and terrestrial environment. Environ. Sci. Pollut. Res. 2020, 27, 12830–12837. [Google Scholar] [CrossRef]
- Verma, S.; Mohanty, S.; Nayak, S.K. A review on protective polymeric coatings for marine applications. J. Coat. Technol. Res 2019, 16, 307–338. [Google Scholar] [CrossRef]
- Verma, S.; Das, S.; Mohanty, S.; Nayak, S.K. A facile preparation of epoxy-polydimethylsiloxane (EP-PDMS) polymer coatings for marine applications. J. Mater. Res. 2019, 34, 2881–2894. [Google Scholar] [CrossRef]
- Korde, J.M.; Sreekumar, A.V.; Kandasubramanian, B. Corrosion inhibition of 316L-type stainless steel under marine environments using epoxy/waste plastic soot coatings. SN Appl. Sci. 2020, 2, 1267. [Google Scholar] [CrossRef]
- Nwuzor, I.C.; Idumah, C.I.; Nwanonenyi, S.C.; Ezeani, O.E. Emerging trends in self-polishing anti-fouling coatings for marine environment. Saf. Extreme Environ. 2021, 3, 9–25. [Google Scholar] [CrossRef]
- Sapronov, O.O.; Buketov, A.V.; Maruschak, P.O.; Panin, S.V.; Brailo, M.V.; Yakushchenko, S.V.; Sapronova, A.V.; Leshchenko, O.V.; Menou, A. Research of crack initiation and propagation under loading for providing impact resilience of protective coating. Funct. Mater. 2019, 26, 114–120. [Google Scholar] [CrossRef]
- Makaryan, I.A.; Kostin, A.Y.; Sedov, I.V. Development of Functional Polymer Coatings Using Supercritical Fluids: Technologies, Markets, and Prospects. Russ. J. Phys. Chem. B 2018, 12, 1132–1143. [Google Scholar] [CrossRef]
- Gholampour, A.; Ozbakkaloglu, T. A review of natural fiber composites: Properties, modification and processing techniques, characterization, applications. J. Mater. Sci. 2020, 55, 829–892. [Google Scholar] [CrossRef]
- Valenkov, A.M.; Shapovalov, V.M. Investigation of the Structure of Surface and Tribological Properties of Composition Coatings Based on Thermosetting Epoxy–Polyester Resins. J. Frict. Wear 2018, 39, 179–182. [Google Scholar] [CrossRef]
- Malysheva, G.V.; Guzeva, T.A. Technological Support for Decreasing the Porosity of Polymer Composite Products. Russ. Metall. (Met.) 2021, 2021, 1692–1695. [Google Scholar] [CrossRef]
- Buketov, A.; Sapronov, O.; Brailo, M.; Stukhlyak, D.; Yakushchenko, S.; Buketova, N.; Sapronova, A.; Sotsenko, V. The Use of Complex Additives for the Formation of Corrosion- and Wear-Resistant Epoxy Composites. Adv. Mater. Sci. Eng. 2019, 2019, 8183761. [Google Scholar] [CrossRef]
- Memon, H.; Wei, Y.; Zhu, C. Recyclable and reformable epoxy resins based on dynamic covalent bonds–Present, past, and future. Polym. Test. 2022, 105, 107420. [Google Scholar] [CrossRef]
- Hu, Q.; Memon, H.; Qiu, Y.; Liu, W.; Wei, Y. A Comprehensive Study on the Mechanical Properties of Different 3D Woven Carbon Fiber-Epoxy Composites. Materials 2020, 13, 2765. [Google Scholar] [CrossRef] [PubMed]
- Mehta, M.; Liu, Y.; Waterland, M.; Holmes, G. Monitoring the mode of action of synthetic and natural biocides against Aeromonas hydrophila by Raman spectroscopy and chemometrics. J. Leather Sci. Eng. 2021, 3, 22. [Google Scholar] [CrossRef]
- Kondratenko, Y.A.; Vlasov, D.Y.; Buslaev, G.S.; Kochina, T.A.; Shilova, O.A. Improving the Bioresistance of Silica-Organic Coatings by Introducing Soft Biocides Based on Intracomplex Compounds of Triethanolamine. Glass Phys. Chem. 2019, 45, 372–378. [Google Scholar] [CrossRef]
- Vesco, S.; Aversa, C.; Puopolo, M.; Barletta, M. Advances in design and manufacturing of environmentally friendly and biocide-free antifouling/foul-release coatings: Replacement of fluorinate species. J. Coat. Technol. Res. 2019, 16, 661–680. [Google Scholar] [CrossRef]
- The European Parlament and the Council of the European Union. Directives 2013/39/EU of 12 August 2013 Amending Directives 2000/60/EC and 2008/105/EC as Regards Priority Substances in the Field of Water Policy; Official Journal of the European Union: Brussels, Belgium, 2013; pp. 1–17. [Google Scholar]
- Ahmad, S.A.; Das, S.S.; Khatoon, A.; Ansari, M.T.; Afzal, M.; Hasnain, M.S.; Nayak, A.K. Bactericidal activity of silver nanoparticles: A mechanistic review. Mater. Sci. Energy Technol. 2020, 3, 756–769. [Google Scholar] [CrossRef]
- Swolana, D.; Wojtyczka, R.D. Activity of Silver Nanoparticles against Staphylococcus spp. Int. J. Mol. Sci. 2022, 23, 4298. [Google Scholar] [CrossRef] [PubMed]
- Zhang, W.; Jiang, H.; Chang, Z.; Wu, W.; Wu, G.; Wu, R.; Li, J. Recent achievements in self-healing materials based on ionic liquids: A review. J. Mater. Sci. 2020, 55, 13543–13558. [Google Scholar] [CrossRef]
- Amelia, T.S.M.; Khalik, W.M.A.W.M.; Ong, M.C.; Shao, Y.T.; Pan, H.J.; Bhubalan, K. Marine microplastics as vectors of major ocean pollutants and its hazards to the marine ecosystem and humans. Prog. Earth Planet. Sci. 2021, 8, 12. [Google Scholar] [CrossRef]
- Bekele, T.G.; Zhao, H.; Yang, J.; Chegen, R.G.; Chen, J.; Mekonen, S.; Qadeer, A. A review of environmental occurrence, analysis, bioaccumulation, and toxicity of organophosphate esters. Environ. Sci. Pollut. Res. 2021, 28, 49507–49528. [Google Scholar] [CrossRef]
- Afanas’ev, V.V.; Yumasheva, T.M.; Bespalova, N.B. Promising Catalytic Processes of Dicyclopentadiene Metathesis Polymerization to Obtain a New Class of Polymeric and Polymer–Composite Materials. Polym. Sci. Ser. C 2019, 61, 31–40. [Google Scholar] [CrossRef]
- Thomaz, S.M. Ecosystem services provided by freshwater macrophytes. Hydrobiologia 2021, 1–21. [Google Scholar] [CrossRef]
- Gross, E.M. Aquatic chemical ecology meets ecotoxicology. Aquat. Ecol. 2022, 56, 493–511. [Google Scholar] [CrossRef]
- Ding, Y.; Huang, C.; Zhu, L.; Feng, J.; Xia, B.; Zhao, X.; Sun, X.; Chen, B.; Qu, K. A Review on Toxic Effects of Engineered Nanoparticles on Marine Fishery Organisms and Their Impact on Quality and Safety of Seafood. Asian J. Ecotoxicol. 2020, 6, 57–71. [Google Scholar]
- Marc, A.; Williams, B.S. Toxicology of Nanoparticles and Nanomaterials in Human, Terrestrial and Aquatic Systems, 1st ed.; Wiley: Hoboken, NJ, USA, 2022. [Google Scholar]
- Pandiarajan, J.; Krishnan, M. Properties, synthesis and toxicity of silver nanoparticles. Environ. Chem. Lett. 2017, 15, 387–397. [Google Scholar] [CrossRef]
- Faria, S.I.; Gomes, L.C.; Teixeira-Santos, R.; Morais, J.; Vasconcelos, V.; Mergulhão, F.J.M. Developing New Marine Antifouling Surfaces: Learning from Single-Strain Laboratory Tests. Coatings 2021, 11, 90. [Google Scholar] [CrossRef]
- Carvalho, C.C. Marine biofilms: A successful microbial strategy with economic implications. Front. Mar. Sci. 2018, 5, 126. [Google Scholar] [CrossRef]
- Magana, M.; Sereti, C.; Ioannidis, A.; Mitchell, C.A.; Ball, A.R.; Magiorkinis, E.; Chatzipanagiotou, S.; Hamblin, M.R.; Hadjifrangiskou, M.; Tegos, G.P. Options and limitations in clinical Investigation of bacterial biofilms. Clin. Microbiol. Rev. 2018, 31, e00084-16. [Google Scholar] [CrossRef]
- Grytsenko, O.; Pukach, P.; Suberlyak, O.; Shakhovska, N.; Karovič, V. Usage of mathematical modeling and optimization in development of hydrogel medical dressings production. Electronics 2021, 10, 620. [Google Scholar] [CrossRef]
- Demchenko, V.; Riabov, S.; Shtompel, V. X-ray study of structural formation and thermomechanical properties of silver-containing polymer nanocomposites. Nanoscale Res. Lett. 2017, 12, 235–240. [Google Scholar] [CrossRef]
- Demchenko, V.L.; Kobylinskyi, S.M.; Rybalchenko, N.P.; Iurzhenko, M.V.; Rokytskyi, M.O.; Demchenko, O.M. Effect of cationic polyelectrolyte on the structure and antimicrobial activity of silver-containing nanocomposites based on interpolyelectrolyte complexes with a pectin anionic component. Appl. Nanosci. 2022, 12, 459–466. [Google Scholar] [CrossRef]
- Legradi, J.B.; Di Paolo, C.; Kraak, M.H.S.; Van der Geest, H.G.; Schymanski, E.L.; Williams, A.J.; Dingemans, M.M.L.; Massei, R.; Brack, W.; Cousin, X.; et al. An ecotoxicological view on neurotoxicity assessment. Environ. Sci. Eur. 2018, 30, 46. [Google Scholar] [CrossRef]
- Verla, A.W.; Enyoh, C.E.; Verla, E.N.; Nwarnorh, K.O. Microplastic–toxic chemical interaction: A review study on quantified levels, mechanism and implication. SN Appl. Sci. 2019, 1, 1400. [Google Scholar] [CrossRef]
- Dyadyura, K.; Ivakhniuk, T.; Hrebenyk, L.; Ivakhniuk, U.; Sukhodub, L. Standardization Issues of Test Methods for Engineering Nanomaterials. In Advanced Manufacturing Processes II, Lecture Notes in Mechanical Engineering; Tonkonogyi, V., Ivanov, V., Trojanowska, J., Oborskyi, G., Grabchenko, A., Pavlenko, I., Edl, M., Kuric, I., Dasic, P., Eds.; Springer: Cham, Switzerland, 2021; pp. 797–805. [Google Scholar]
- Moldanová, J.; Hassellöv, I.M.; Matthias, V.; Fridell, E.; Jalkanen, J.P.; Ytreberg, E.; Quante, M.; Tröltzsch, J.; Maljutenko, I.; Raudsepp, U.; et al. Framework for the environmental impact assessment of operational shipping. Ambio 2022, 51, 754–769. [Google Scholar] [CrossRef] [PubMed]
- Brack, W. Solutions for present and future emerging pollutants in land and water resources management. Policy briefs summarizing scientific project results for decision makers. Environ. Sci. Eur. 2019, 31, 74. [Google Scholar] [CrossRef]
- Denisov, D.B.; Chernova, E.N.; Russkikh, I.V. Toxic Cyanobacteria in the Arctic Lakes: New Environmental Challenges. A Case Study. In Advanced Technologies for Sustainable Development of Urban Green Infrastructure; Springer: Cham, Switzerland, 2021; pp. 161–170. [Google Scholar]
- Dike, S.; Apte, S.; Tiwari, A.K. Micro-plastic pollution in marine, freshwater and soil environment: A research and patent analysis. Int. J. Environ. Sci. Technol. 2021, 1–28. [Google Scholar] [CrossRef]
- Jain, M.; Mudhoo, A.; Ramasamy, D.L.; Najafi, M.; Usman, M.; Zhu, R.; Kumar, G.; Shobana, S.; Garg, V.K.; Sillanpää, M. Adsorption, degradation, and mineralization of emerging pollutants (pharmaceuticals and agrochemicals) by nanostructures: A comprehensive review. Environ. Sci. Pollut. Res. 2020, 27, 34862–34905. [Google Scholar] [CrossRef] [PubMed]
- Tistechok, S.; Skvortsova, M.; Mytsyk, Y.; Fedorenko, V.; Parnikoza, I.; Luzhetskyy, A.; Gromyko, O. The diversity and antibacterial activity of culturable actinobacteria isolated from the rhizosphere soil of Deschampsia antarctica (Galindez Island, Maritime Antarctic). Polar Biol. 2021, 44, 1859–1868. [Google Scholar] [CrossRef]
- Buketov, A.; Yakushchenko, S.; Menou, A.; Bezbakh, O.; Vrublevskyi, R.; Kalba, Y.; Cherniavska, T.; Zhytnyk, D.; Danylyuk, O. Optimization of ingredients upon development of the protective polymeric composite coatings for the river and sea transport. Commun. Sci. Lett. Univ. Zilina 2021, 23, B89–B96. [Google Scholar] [CrossRef]
- Buketov, A.; Yakushchenko, S.; Cherniavska, T.; Zhytnyk, D.; Buketova, N.; Ivchenko, T.; Fesenko, I.; Negrutsa, R. Optimization of Ingredients for Two-Layer Epoxy Coating for Protection of Sea and River Vehicles. In Advances in Intelligent Systems and Computing. Lecture Notes in Computational Intelligence and Decision Making; Babichev, S., Lytvynenko, V., Wójcik, W., Vyshemyrskaya, S., Eds.; Springer: Cham, Switzerland, 2020; Volume 1246, pp. 612–626. [Google Scholar]
- Bunke, D.; Moritz, S.; Brack, W.; Herráez, D.L.; Posthuma, L.; Nuss, M. Developments in society and implications for emerging pollutants in the aquatic environment. Environ. Sci. Eur. 2019, 31, 32. [Google Scholar] [CrossRef]
- Brailo, M.; Buketov, A.; Yakushchenko, S.; Sapronov, O.; Vynar, V.; Kobelnik, O. The Investigation of Tribological Properties of Epoxy-Polyether Composite Materials for Using in the Friction Units of Means of Sea Transport. Mater. Perform. Charact. 2018, 7, 275–299. [Google Scholar] [CrossRef]
- Buketov, A.; Brailo, M.; Yakushchenko, S.; Sapronov, O.; Vynar, V.; Bezbakh, O.; Negros, R. Investigation of Tribological Properties of Two-Component Bidisperse Epoxy-Polyester Composite Materials for Its Use in the Friction Units of Means of Sea Transport. Period. Polytech. Mech. Eng. 2019, 63, 171–182. [Google Scholar] [CrossRef]
- Banu, A.N.; Kudesia, N.; Raut, A.M.; Pakrudheen, I.; Wahengbam, J. Toxicity, bioaccumulation, and transformation of silver nanoparticles in aqua biota: A review. Environ. Chem. Lett. 2021, 19, 4275–4296. [Google Scholar] [CrossRef]
- Gupta, D.; Yadav, P.; Garg, D.; Gupta, T.K. Pathways of nanotoxicity: Modes of detection, impact, and challenges. Front. Mater. Sci. 2021, 15, 512–542. [Google Scholar] [CrossRef]
- Hamad, A.; Khashan, K.S.; Hadi, A. Silver Nanoparticles and Silver Ions as Potential Antibacterial Agents. J. Inorg. Organomet. Polym. Mater. 2020, 30, 4811–4828. [Google Scholar] [CrossRef]

| Main Components | Factor | Average Level, q, wt% | Coefficient of Variation, Δq, wt% | Values of the Levels of Variables (wt%) of Corresponding to Conventional Units | ||
|---|---|---|---|---|---|---|
| −1 | 0 | +1 | ||||
| Oxytetracycline | x1 | 1.0 | 0.5 | 0.5 | 1.0 | 1.5 |
| Nanosilver | x2 | 0.075 | 0.025 | 0.050 | 0.075 | 0.100 |
| Experiment Number (u) | x0 | x1 | x2 | |||
|---|---|---|---|---|---|---|
| 1 | 1 | −1 | −1 | 0.33 | 0.33 | +1 |
| 2 | 1 | +1 | −1 | 0.33 | 0.33 | −1 |
| 3 | 1 | −1 | +1 | 0.33 | 0.33 | −1 |
| 4 | 1 | +1 | +1 | 0.33 | 0.33 | +1 |
| 5 | 1 | 0 | 0 | −0.67 | −0.67 | 0 |
| 6 | 1 | +1 | 0 | 0.33 | −0.67 | 0 |
| 7 | 1 | −1 | 0 | 0.33 | −0.67 | 0 |
| 8 | 1 | 0 | +1 | −0.67 | 0.33 | 0 |
| 9 | 1 | 0 | −1 | −0.67 | 0.33 | 0 |
| 9 | 6 | 6 | 2 | 2 | 4 |
| The Experiment Number | The Contents of the Component q, wt%. | The Flexural Strength, Rbm, MPa | The Flexural Modulus E, GPa | |
|---|---|---|---|---|
| x1 | x2 | y | y2 | |
| 1 | 0.5 | 0.050 | 92.4 | 3.1 |
| 2 | 1.5 | 0.050 | 82.5 | 2.7 |
| 3 | 0.5 | 0.100 | 80.1 | 2.8 |
| 4 | 1.5 | 0.100 | 83.2 | 2.8 |
| 5 | 1.0 | 0.075 | 81.5 | 2.9 |
| 6 | 1.5 | 0.075 | 87.7 | 3.3 |
| 7 | 0.5 | 0.075 | 84.5 | 3.0 |
| 18 | 1.0 | 0.100 | 80.4 | 2.7 |
| 9 | 1.0 | 0.050 | 82.7 | 2.8 |
| b0 | b1 | b2 | b11 | b22 | b12 |
|---|---|---|---|---|---|
| 82.21 | −0.60 | −2.32 | 3.53 | −1.02 | 3.25 |
| Experiment Number | Adequacy Variance | Reproduced Variances | ||
|---|---|---|---|---|
| Symbol | Value | Symbol | Value | |
| 1 | 0.01 | 0.02 | ||
| 2 | 0.03 | 0.06 | ||
| 3 | 0.01 | 0.02 | ||
| 4 | 0.04 | 0.08 | ||
| 5 | 0.03 | 0.06 | ||
| 6 | 0.04 | 0.08 | ||
| 7 | 0.03 | 0.06 | ||
| 8 | 0.03 | 0.06 | ||
| 9 | 0.01 | 0.02 | ||
| Experiment Number | Flexural Strength, Rbm, MPa | Average Value, Rbm, MPa | ||
|---|---|---|---|---|
| 1 | 2 | 3 | ||
| 1 | 92.5 | 92.3 | 92.4 | 92.4 |
| 2 | 82.7 | 82.4 | 82.4 | 82.5 |
| 3 | 80.0 | 80.2 | 80.1 | 80.1 |
| 4 | 83.4 | 83.2 | 83.0 | 83.2 |
| 5 | 81.3 | 81.6 | 81.6 | 81.5 |
| 6 | 87.9 | 87.5 | 87.7 | 87.7 |
| 7 | 84.6 | 84.6 | 84.3 | 84.5 |
| 8 | 80.5 | 80.5 | 80.2 | 80.4 |
| 9 | 82.7 | 82.8 | 82.6 | 82.7 |
| Experiment Number | Dispersion of the Regression Coefficients | Calculated Values of Student’s t-tests | ||
|---|---|---|---|---|
| Symbol | Value | Symbol | Value | |
| 1 | 0.003 | t0p | 1515.96 | |
| 2 | 0.004 | t1p | 9.19 | |
| 3 | 0.004 | t2p | 35.50 | |
| 4 | 0.013 | t11p | 31.26 | |
| 5 | 0.013 | t22p | 8.99 | |
| 6 | 0.006 | t12p | 40.7 | |
| b0 | b1 | b2 | b11 | b22 | b12 |
|---|---|---|---|---|---|
| 2.97 | −0.02 | −0.05 | 0.15 | −0.25 | 0.10 |
| Experiment Number | Adequacy Variance | Reproduced Variances | ||
|---|---|---|---|---|
| Symbol | Value | Symbol | Value | |
| 1 | 0.003 | 0.005 | ||
| 2 | 0.005 | 0.010 | ||
| 3 | 0.006 | 0.013 | ||
| 4 | 0.003 | 0.005 | ||
| 5 | 0.014 | 0.029 | ||
| 6 | 0.004 | 0.007 | ||
| 7 | 0.020 | 0.039 | ||
| 8 | 0.002 | 0.005 | ||
| 9 | 0.010 | 0.020 | ||
| Experiment Number | Flexural Modulus, E, GPa | Average Value, E, GPa | ||
|---|---|---|---|---|
| 1 | 2 | 3 | ||
| 1 | 3.05 | 3.10 | 3.15 | 3.1 |
| 2 | 2.75 | 2.73 | 2.62 | 2.7 |
| 3 | 2.88 | 2.80 | 2.72 | 2.8 |
| 4 | 2.85 | 2.80 | 2.75 | 2.8 |
| 5 | 2.78 | 2.90 | 3.02 | 2.9 |
| 6 | 3.36 | 3.30 | 3.24 | 3.3 |
| 7 | 3.00 | 2.86 | 3.14 | 3.0 |
| 8 | 2.70 | 2.75 | 2.65 | 2.7 |
| 9 | 2.80 | 2.90 | 2.70 | 2.8 |
| Experiment Number | Dispersion of the Coefficients of the Polynomial Derived | Calculated Values of Student’s t-tests | ||
|---|---|---|---|---|
| Symbol | Value | Symbol | Value | |
| 1 | 0.001 | t0p | 99.23 | |
| 2 | 0.001 | t1p | 0.48 | |
| 3 | 0.001 | t2p | 1.43 | |
| 4 | 0.004 | t11p | 2.47 | |
| 5 | 0.004 | t22p | 4.12 | |
| 6 | 0.002 | t12p | 2.30 | |
| Sequence Number of the Sample | Type of Filler and Its Content in the Epoxy Oligomer DER-331 |
|---|---|
| 1 | Epoxy matrix DER-331 |
| 2 | Oxytetracycline of the content q = 0.5 wt% (pointed to 100 wt% epoxy DER-331) |
| 3 | Oxytetracycline of the content q = 1.0 wt% |
| 4 | Oxytetracycline of the content q = 1.5 wt% |
| 5 | Nanosilver of the content q = 0.050 wt% (dispersibility 10–100 nm) |
| 6 | Nanosilver of the content q = 0.075 wt% (dispersibility 10–100 nm) |
| 7 | Nanosilver of the content q = 0.100 wt% (dispersibility 10–100 nm) |
| 8 | Control steel sample without coating (Steel Grade-Fe360-C) |
| 9 | Oxytetracycline of the content q = 0.5 wt%. + Nanosilver of the content q = 0.075 wt%. |
| 10 | Oxytetracycline of the content q = 0.5 wt%. + Nanosilver of the content q = 0.050 wt%. |
| 11 | Oxytetracycline of the content q = 1.5 wt%. + Nanosilver of the content q = 0.075 wt%. |
| Sequence Number of the Sample | Type of Filler and Its Content in the Epoxy Oligomer DER-331 | Initial/Final Number of Test Cultures, lg CFU/mL | ||
|---|---|---|---|---|
| Lactobacillus acidophilus | Bifidobacterium bifidum | Escherichia coli | ||
| 2 | Control steel sample without coating (Steel Grade-Fe360-C) | 2.0/4.0 | 2.0/2.82 | 2.0/3.21 |
| 3 | Oxytetracycline on the content q = 0.5 wt% (pointed to 100 wt% epoxy DER-331) | 2.0/2.34 | 2.0/2.34 | 2.0/2.34 |
| 4 | Oxytetracycline on the content q = 1.0 wt%. | 2.0/2.10 | 2.0/2.11 | 2.0/2.11 |
| 5 | Oxytetracycline on the content q = 1.5 wt% | 2.0/2.11 | 2.0/1.57 | 2.0/1.57 |
| 6 | Nanosilver on the content q = 0.050 wt% (dispersibility 10–100 nm) | 2.0/2.40 | 2.0/2.27 | 2.0/2.27 |
| 7 | Nanosilver on the content q = 0.075 wt% (dispersibility 10–100 nm) | 2.0/2.36 | 2.0/2.43 | 2.0/2.43 |
| 8 | Nanosilver on the content q = 0.100 wt% (dispersibility 10–100 nm) | 2.0/2.35 | 2.0/2.43 | 2.0/2.42 |
| 9 | Oxytetracycline on the content q = 0.5 wt% + Nanosilver on the content q = 0.075 wt% | 2.0/2.08 | 2.0/2.59 | 2.0/2.59 |
| 10 | Oxytetracycline on the content q = 0.5 wt% + Nanosilver on the content q = 0.050 wt% | 2.0/2.48 | 2.0/2.69 | 2.0/2.69 |
| 11 | Oxytetracycline on the content q = 1.5 wt% + Nanosilver on the content q = 0.075 wt% | 2.0/1.89 | 2.0/1.04 | 2.0/1.05 |
Publisher’s Note: MDPI stays neutral with regard to jurisdictional claims in published maps and institutional affiliations. |
© 2022 by the authors. Licensee MDPI, Basel, Switzerland. This article is an open access article distributed under the terms and conditions of the Creative Commons Attribution (CC BY) license (https://creativecommons.org/licenses/by/4.0/).
Share and Cite
Panda, A.; Dyadyura, K.; Valíček, J.; Harničárová, M.; Kušnerová, M.; Ivakhniuk, T.; Hrebenyk, L.; Sapronov, O.; Sotsenko, V.; Vorobiov, P.; et al. Ecotoxicity Study of New Composite Materials Based on Epoxy Matrix DER-331 Filled with Biocides Used for Industrial Applications. Polymers 2022, 14, 3275. https://doi.org/10.3390/polym14163275
Panda A, Dyadyura K, Valíček J, Harničárová M, Kušnerová M, Ivakhniuk T, Hrebenyk L, Sapronov O, Sotsenko V, Vorobiov P, et al. Ecotoxicity Study of New Composite Materials Based on Epoxy Matrix DER-331 Filled with Biocides Used for Industrial Applications. Polymers. 2022; 14(16):3275. https://doi.org/10.3390/polym14163275
Chicago/Turabian StylePanda, Anton, Kostiantyn Dyadyura, Jan Valíček, Marta Harničárová, Milena Kušnerová, Tatyana Ivakhniuk, Liudmyla Hrebenyk, Oleksandr Sapronov, Vitalii Sotsenko, Pavlo Vorobiov, and et al. 2022. "Ecotoxicity Study of New Composite Materials Based on Epoxy Matrix DER-331 Filled with Biocides Used for Industrial Applications" Polymers 14, no. 16: 3275. https://doi.org/10.3390/polym14163275
APA StylePanda, A., Dyadyura, K., Valíček, J., Harničárová, M., Kušnerová, M., Ivakhniuk, T., Hrebenyk, L., Sapronov, O., Sotsenko, V., Vorobiov, P., Levytskyi, V., Buketov, A., & Pandová, I. (2022). Ecotoxicity Study of New Composite Materials Based on Epoxy Matrix DER-331 Filled with Biocides Used for Industrial Applications. Polymers, 14(16), 3275. https://doi.org/10.3390/polym14163275

